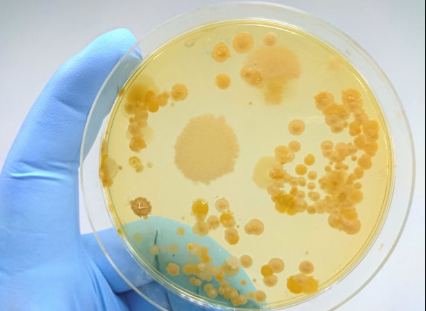

培養(yǎng)基(Medium),是指供給微生物、植物或動物(或組織)生長繁殖的,由不同營養(yǎng)物質組合配制而成的營養(yǎng)基質。一般都含有碳水化合物、含氮物質、無機鹽(包括微量元素)、維生素和水等幾大類物質。培養(yǎng)基既是提供細胞營養(yǎng)和促使細胞增殖的基礎物質,也是細胞生長和繁殖的生存環(huán)境。

培養(yǎng)基種類很多,
1. 根據配制原料的來源可分為自然培養(yǎng)基、合成培養(yǎng)基、半合成培養(yǎng)基;
2. 根據物理狀態(tài)可分為固體培養(yǎng)基、液體培養(yǎng)基、半固體培養(yǎng)基;
3. 根據培養(yǎng)功能可分為基礎培養(yǎng)基、選擇培養(yǎng)基、加富培養(yǎng)基、鑒別培養(yǎng)基等;
4. 根據使用范圍可分為細菌培養(yǎng)基、放線菌培養(yǎng)基、酵母菌培養(yǎng)基、真菌培養(yǎng)基等。培養(yǎng)基配成后一般需測試并調節(jié)pH,還須進行滅菌,通常有高溫滅菌和過濾滅菌。
培養(yǎng)基由于富含營養(yǎng)物質,易被污染或變質。配好后不宜久置,最好現配現用,常見問題如下:
1.低血清培養(yǎng)基能用肉眼判斷其pH值嗎?
答:低血清培養(yǎng)基中酚紅的含量與普通培養(yǎng)基中的酚紅含量不同,不能通過肉眼觀察或通過經驗來判定pH值,建議使用pH計進行測定。
2.低血清培養(yǎng)基的緩沖系統(tǒng)是什么?
答:平衡鹽一般是由無機鹽及葡萄糖組成的。平衡鹽有Hanks′系統(tǒng)、Earle′s系統(tǒng)、Dulbecco′s磷酸緩沖鹽系統(tǒng)等。199系列培養(yǎng)基、MEM系列培養(yǎng)基均有Hanks′系統(tǒng)的培養(yǎng)基及Earle′s系統(tǒng)的培養(yǎng)基。但是有些培養(yǎng)基均不是以上常規(guī)的平衡鹽系統(tǒng),例如RPMI 1640培養(yǎng)基、F12培養(yǎng)基。MEM(SLM)低血清培養(yǎng)基的平衡鹽系統(tǒng)也不是常規(guī)的平衡鹽系統(tǒng),該平衡鹽系統(tǒng)的緩沖能力強于常規(guī)平衡鹽系統(tǒng)的緩沖能力。
3.谷氨酰胺溶液和碳酸氫鈉的配制方法是什么?
答:以0.2mol/L的 L-谷氨酰胺配制為例:稱取L-谷氨酰胺2.92g,加注射用水100ml,充分攪拌混勻。用0.2μm濾膜正壓過濾除菌。溶液應在4℃下避光保存,2周內使用。以7.5% NaHCO3的配制為例:稱取NaHCO37.5g溶于100ml蒸餾水中過濾除菌。
4.什么培養(yǎng)基中可以省去加酚紅?
答:酚紅在培養(yǎng)基中用作pH值的指示劑:中性時為紅色,酸性時為黃色,堿性時為紫色。酚紅本身對生物制品質量并不會產生影響,可以通過純化技術去除,但酚紅在無血清培養(yǎng)基可能帶來胞內鈉/鉀失衡,影響細胞生長,當然這種作用能被血清所中和或減輕。 酚紅并不是培養(yǎng)基中必需的一種成分,很多國外的疫苗或抗體生產企業(yè)在生產過程中都使用無酚紅培養(yǎng)基。
5.放置在冰箱中的培養(yǎng)基顏色會發(fā)生變化,為什么?
答:培養(yǎng)基保存于4℃冰箱中,培養(yǎng)基內CO2 會逐漸溢出,造成培養(yǎng)基越來越偏堿性。而培養(yǎng)基中酸堿指示劑(通常為phenol red)的顏色也會隨堿性增加而更偏暗紅。培養(yǎng)基偏堿后再用于細胞培養(yǎng)將造成細胞生長停滯或死亡。培養(yǎng)基偏堿時,可以通入無菌過濾的CO2,以調整pH值。
6.無血清培養(yǎng)與有血清培養(yǎng)使用的抗生素量一樣嗎?
答:當在無血清培養(yǎng)基中添加抗生素時,降低至少在有血清培養(yǎng)基中所使用濃度的50%。因為血清中的蛋白會結合和滅活一些抗生素。而在無血清培養(yǎng)條件下,抗生素不被滅活。